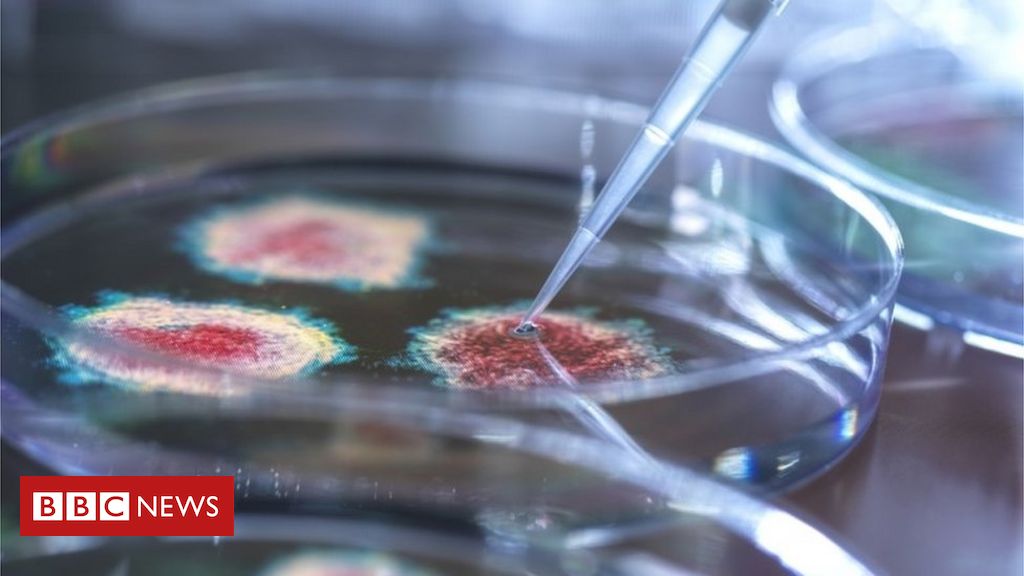

Officially, hundreds of children have lost both their parents. Experts say the number may be much higher.
Source link
Next Post
Biosecurity warning over loosely-regulated virus labs
Sun May 30 , 2021
Governments do not have controls to stop terrorists accessing labs and posing a biological threat. Source link